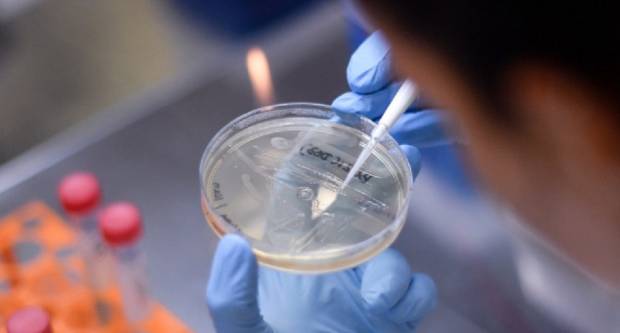

UPRAVO
MLADOST, VJERA I ZAJEDNIŠTVO: Tisuće hodočasnika preplavile Požegu na Susretu hrvatske katoličke mladeži
SHKM 2026. Požega
Nepokošena Dubrovačka ulica dočekuje tisuće mladih – slika koja ne priliči Požegi
Sve informacije o susretu na jednom mjestu uz aplikaciju „SHKM 2026.“
ARHIVE: Dan kada je požeški „Patak“ pobijedio radijaciju
Obiteljska biciklijada okupila brojne generacije na ulicama Požege
Pilana Spin Valisa u Požegi pred prodajom: General Jozo Jović među glavnim kandidatima!?
Održano predavanje i predstavljene knjige Jasenke Kranjčević o djelima čeških arhitekata u Hrvatskoj
Drska provala u Požegi: iz kuće 74-godišnjakinje nestao novac
Tiha počast za veliku pobjedu: obilježena obljetnica „Bljeska“
Weather for the Following Location: Pozega map, Croatia

24sata
Pronađeno rezultata: 20
Prikazuje se stranica 1/1
Hrvatska danas ima preko 4000 novopozitivnih osoba, preminula 51 osoba
U posljednja 24 sata u RH su zabilježena 2323 nova slučaja zaraze virusom
U posljednja 24 sata zabilježena su 3164 nova slučaja zaraze korona virusom
U posljednja 24 sata zabilježen je 3251 novi slučaj zaraze virusom
U posljednja 24 sata u Hrvatskoj je zabilježeno 1945 novih slučajeva zaraze korona virusom
U posljednja 24 sata u HR zabilježeno je 2365 novih slučajeva zaraze korona virusom
U posljednja 24 sata u HR zabilježeno 2866 novih slučajeva zaraze korona virusom
U posljednja 24 sata zabilježeno je 2597 novih slučajeva zaraze virusom SARS-CoV-2
Nacionalni stožer objavio najnovije podatke, ukupni broj zaraženih od početka epidemije prešao 70 tisuća
U posljednja 24 sata zabilježeno je 1529 novih slučajeva zaraze virusom SARS-CoV-2
Nacionalni stožer objavio podatke, veliki broj pacijenata na bolničkom liječenju
U Hrvatskoj danas 2179 novozaraženih, 16 ljudi preminulo
U Hrvatskoj danas preko 2700 novozaraženih
Hrvatska srušila crni rekord novooboljelih
Najgori dan do sada, prešli smo 2000 novooboljelih
U posljednja 24 sata u Hrvatskoj su zabilježena 393 nova slučaja zaraze virusom
Danas očekivano nešto manji broj novooboljelih
OPET NOVI REKORD: Hrvatska danas ima 793 novozaraženih koronavirusom
I danas velik broj novozaraženih u Hrvatskoj
Požežanka Angelica Legac rodila se sa 980 grama, danas osvaja medalju za medaljom, i mnogo više od toga !!!!
Oglašavajte se na 034 portalu jer:
više od 300.000 korisnika mjesečno
više od 2 milijuna otvaranja stranica svakog mjeseca